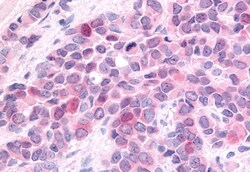
Invitrogen HUNK Polyclonal Antibody 50 &mu;g; Unconjugated:Antibodies,
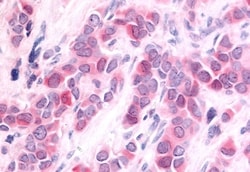
Invitrogen HUNK Polyclonal Antibody 50 &mu;g; Unconjugated:Antibodies,

missing translation for 'onlineSavingsMsg'
Learn More
Learn More
Invitrogen™ HUNK Polyclonal Antibody


Rabbit Polyclonal Antibody
Brand: Invitrogen™ PA533856
This item is not returnable.
View return policy
Description
Percent identity with other species by BLAST analysis: Human, Chimpanzee, Gorilla, Gibbon, Monkey, Marmoset (100%).
HUNK serine/threonine kinase or hormonally up-regulated Neu-associated kinase is a member of the mitogen-activated protein kinase family which is essential for mammary tumor metastasis. HUNK deletion in mice did not alter viability, fertility, longevity, or propensity to develop tumors and it is also dispensable for murine development. HUNK has been shown to participate in vesicular transport. Additionally, functional studies in mice suggest that HUNK regulates endocytosis via interaction with rabaptin-5 protein and induces changes in mammary glands during pregnancy. HUNK expression has been documented in mouse brain, breast, embryo, and fetus. ESTs have been isolated from several human tissue libraries, including normal ear.
Specifications
| HUNK | |
| Polyclonal | |
| Unconjugated | |
| HUNK | |
| B19; Bstk1; Hormonally up-regulated neu tumor-associated kinase; hormonally upregulated neu tumor-associated kinase; hormonally up-regulated Neu-associated kinase; hormonally upregulated Neu-associated kinase; Hunk; MAKV; Mak-v; RGD1565091; serine/threonine protein kinase MAK-V; serine/threonine-protein kinase MAK-V | |
| Rabbit | |
| Antigen affinity chromatography | |
| RUO | |
| 30811 | |
| Store at 4°C short term. For long term storage, store at -20°C, avoiding freeze/thaw cycles. | |
| Liquid |
| Immunohistochemistry (Paraffin) | |
| 1 mg/mL | |
| PBS with 0.1% sodium azide | |
| P57058 | |
| HUNK | |
| Synthetic 18 amino acid peptide from internal region of human HUNK. | |
| 50 μg | |
| Primary | |
| Human, Monkey | |
| Antibody | |
| IgG |
Product Content Correction
Your input is important to us. Please complete this form to provide feedback related to the content on this product.
Product Title
Spot an opportunity for improvement?Share a Content Correction